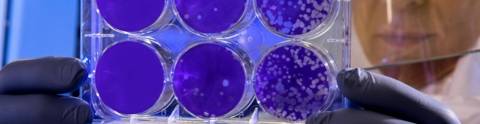
Biotec_hero_02

Objetivos
El Programa pretende desarrollar una formación específica actualizada y útil para la práctica profesional e investigadora en diferentes ámbitos de la bioseguridad tanto en el ámbito público como en el privado.
Este curso contempla un conjunto de materias en línea con el contenido específico que sugieren diferentes normas internacionales en bioseguridad, en especial la ISO 35001 sobre Gestión del Riesgo Biológico.
Objetivos principales:
-Entender el concepto de bioseguridad,
-Conocer las legislaciones, normas y las guías nacionales e internacionales sobre bioseguridad,
-Conocer la clasificación de los agentes biológicos patógenos de implicación en humanos y zoonósicos: Grupos de Riesgo
-Conocer las posibles infecciones profesionales que han conducido al desarrollo de las actuales prácticas de bioseguridad;
-Proveer conocimientos para identificar y analizar riesgos y peligros asociados a la bioseguridad y seguridad laboral en el laboratorio.
-Capacitar para posibilitar la intervención en el análisis de riesgo biológico y en consecuencia, conocer el contenido y desarrollo de una la evaluación de riesgos biológicos en su conjunto y poder interpretar las medidas de prevención,
-Conocer y saber distinguir los detalles de los distintos tipos de contención y sus limitaciones,
-Comprender los riesgos asociados al uso de material biológico y ser consciente de otros peligros en el lugar de trabajo,
-Comprender los tipos de barreras de bioconteción existentes,
-Capacitar acerca de las Buenas Prácticas de Laboratorio para posibilitar su implementación,
-Conocer los métodos de envío de material biológico,
-Aprender a diseñar medidas adecuadas para prevenir el escape de material biológico al medio ambiente,
-Distinguir entre los diferentes niveles de biocontención para laboratorios de investigación y diagnóstico
-Distinguir entre los diferentes niveles de biocontención para instalaciones d experimentación animal con pequeños y grandes animales,
-Brindar herramientas para posibilitar la participación en el diseño y desarrollo de instalaciones con diferentes niveles de bioseguridad,
-Identificar los aspectos de diseño y construcción de las instalaciones que sean necesarias para la gestión del riesgo biológico, establecidos en el proceso de evaluación del riesgo, incluyendo aspectos de seguridad física,
-Proporcionar y fortalecer los conocimientos sobre residuos de laboratorio, para intervenir en el desarrollo y ejecución de planes de manejo o gestión en el laboratorio de bioseguridad,
-Conocer los sistemas de tratamiento del aire y filtración
-Conocer los las diferentes metodologías de tratamiento de efluentes altamente biocontaminados,
-Conocer, comprender y distinguir entre sistemas de tratamiento de descontaminación o esterilización de sólidos ya sean estos reutilizables o desechables,
-Comprender la cualificación técnica y microbiológica del equipamiento de barrera,
-Diferenciar y poder elegir los descontaminantes químicos existentes
-Conocer y diferenciar el tipo y uso de los equipos de protección individual requeridos en una situación determinada,
-Comprender los métodos actuales de desinfección, descontaminación y esterilización,
-Brindar conocimientos para participar en el desarrollo y la ejecución de planes de emergencia y evacuación o contingencia en el laboratorio.
-Poder participar realizar o defender auditorías e inspecciones de bioseguridad y bioprotección.
Requisitos previos
Cursar estudios de un Título de Grado en ciencias biomédicas (Biología, Farmacia, Medicina, Veterinaria, Genética, Microbiología, Ciencias ambientales, Biotecnología, Biomedicina, Bioquímica etc.), ingeniería o arquitectura.
Competencias
COMPETENCIAS GENERALES
CG1 - Pensar de forma integrada, razonar críticamente y abordar los problemas desde diferentes perspectivas.
CG2 – Saber obtener, procesar, interpretar, analizar y sintetizar información y resultados relevantes y obtener conclusiones en temas relacionados con la Biotecnología.
CG3 - Tener capacidad para utilizar fuentes de información internacionales, así como para comunicarse en una segunda lengua de relevancia internacional.
CG6. - Estudiar y aprender de forma autónoma, con organización y planificación del trabajo y adquirir capacidad para trabajar en equipo y autoconfianza.
CG8.- Comprometerse con la ética y la responsabilidad como ciudadano y como profesional.
CE2.- Trabajar de forma adecuada en un laboratorio aplicando los principios básicos de seguridad, manipulación y eliminación de residuos y realizando un registro anotado de actividades.
Resultados de aprendizaje
• Conocer el concepto de bioseguridad y comprender su importancia en el laboratorio
• Conocer los sistemas y mecanismos de protección personal y de las instalaciones
• Conocer las principales medidas de bioseguridad a adoptar para prevenir la entrada y/o diseminación de patógenos en los laboratorios e instalaciones
Descripción de los contenidos
FUNDAMENTOS Y PRINCIPIOS GENERALES
Tema 1: Agentes causantes de enfermedades
- La virosfera
- Enfermedades emergentes y reemergentes,
- Agentes acusantes.
Tema 2. Principios de bioseguridad.
- Conceptos básicos.
- Grupos de Riesgo
- Barreas de contención
Tema 3. Legislación
Conocer, entender y aplicar el marco legislativo y normativo.
- Legislación aplicada a instalaciones
- Legislación aplicada a agentes biológicos: agentes silvestres y OMG
- Normativa nacional aplicada a diseño de instalaciones
- Guías y normas internacionales: OMS, OIE, CDC
- UNE 171400. Diseño de Instalaciones NCB3
Tema 4. Gestión del riesgo biológico,
- Gestión del Riesgo Biológico: ISO 35001
Tema 5. Evaluación del Riesgo Biológico
Evaluación del Riesgo como parte integrante de la Gestión del Riesgo Biológico
Recogida de los hechos relevantes, evaluarlos y proponer medidas correctivas para prevenir o mitigar los accidentes o incidentes recurrentes.
- Evaluación del Riesgo: Metodología
- Identificación de peligros: el check-list en bioseguridad
- Análisis de puestos de trabajo
- Notificación y autorización de actividad con riesgo biológico
Tema 6. La higiene industrial
- Concepto de contaminación (contaminantes físicos, químicos y biológicos)
- Clasificación de los agentes químicos contaminantes (clasificación según se estructura química y según sus propiedades físicas)
- Clasificación de los agentes biológicos contaminantes (virus, bacterias, hongos y protozoos)
- Microorganismos e infecciones laborales
- Toxinas y alérgenos
- Alérgenos e hipersensibilidad;
- Formas de transmisión
- Sistemas de clasificación en grupos de riesgo (Organización Mundial de la Salud (OMS)
- Focos y orígenes de contaminantes
- Dosis infectiva
- Clasificación de los agentes físicos contaminantes (ruido, vibraciones, calor y radiaciones ionizantes y no ionizantes)
- Identificación y evaluación de los riesgos
- Detección de los agentes contaminantes y prevención
Tema 7. Transmisión de patógenos
- Vías,
- Por superficie,
- Aerotransmisión. Transmisión por bioaerosol
- Aplicación a SARS-CoV-2
Tema 8. Incendios aplicado a instalaciones de biocontención
- Química del fuego
- Detección,
- Medios de Extinción,
- Pánico de masas,
- Evacuación del área biocontenida,
- Puntos de encuentro
INSTALACIONES DE BIOSEGURIDAD
Tema 1. Diseño de un Laboratorio Biocontenido.
Diseño y operación de instalaciones biocontenidas para diagnostico e investigación “in vivo” e “in vitro”
- Nivel de contención 2,
- Nivel de contención 3,
- Nivel de contención 4
Tema 2. Diseño de un área de experimentación.
Diseño y operación de instalaciones biocontenidas para pequeños y grandes animales
- Nivel de contención 2,
- Nivel de contención 3,
- Nivel de contención 4
- Situación en la zona NCB3
- Legislación.
- Materiales constructivos. Paredes, suelos, puertas y ventanas
- Pasillos de acceso y salida. Flujo de personas, materiales, animales y residuos.
Tema 3. Principios generales de construcción e ingeniería en contención biológica.
Entender los procesos de construcción, tener conocimiento sobre las características de diseño básico.
- Equipo de diseño (arquitectos e ingenieros, investigadores, seguridad, mantenimiento);
- Puertas y ventanas
- Sistemas de fontanería y vacío;
- Sistemas de control de acceso;
- Materiales de construcción y acabados;
Tema 4. Ventilación, Presión negativa y Filtración del aire.
- Flujo de aire y presiones diferenciales;
- Generación de la presión negativa.
- Steps de presión.
- Tipos de cajas de filtración
- Mecanismos físicos de la filtración
- Requerimientos de la filtración y la ventilación. Redundancia
- El filtro HEPA; su colocación y retirada.
Tema 5. Tratamiento de efluentes altamente biocontaminados.
- Tratamiento de efluentes. Generalidades
- Situación en el área biocontenida
- Sistema químico,
- Sistema térmico,
- Sistema termoquímico,
- Solcher
- Tratamiento de residuos sólidos. Generalidades
Tema 6. Tratamiento de sólidos.
- Gestión de residuos sólidos
- Tratamiento de residuos sólidos. Generalidades
- El autoclave,
- Incineración,
- Plasma
BARRERAS DE BIOSEGURIDAD
Tema 1. Gestión de la entrada y salida de personas, materiales, residuos, animales y plantas.
- Vestuarios de sucio y limpio
- Accesos a laboratorio,
- Accesos a animalarios,
- Accesos a salas de necropsias,
- Salidas
- Duchas de descontaminación de agua y de aire
Tema 2. Elementos de barrera para materiales.
Impacto en la bioseguridad y bioprotección cuando se usan equipos de infraestructura. Elección, instalación, validación, certificación y mantenimiento.
- Autoclaves,
- Dunk Tank
- Airlocks,
- Pastrough (SAS)
Tema 3. Cabinas de Seguridad Biológica
- Tipos,
- Elección,
- Instalación
- Ubicación
- Medidas de uso y seguridad
BIOSEGURIDAD APLICADA
Tema 1. Validación, certificación y mantenimiento de equipamiento.
- Cabinas de seguridad biológica y aisladores,
- Autoclaves,
Tema 2. Control de la infección, desinfección, descontaminación y esterilización.
Validación de procesos de desinfección, descontaminación y esterilización.
- Plan de limpieza
- Fundamentos del control de la infección, desinfección, descontaminación y esterilización;
- Métodos de desinfección, descontaminación y esterilización;
- Principios y métodos de validación,
- Seguimiento
Tema 3. Embalaje, envío, transporte, importación y exportación de material biológico.
Identificar requisitos y restricciones pertinentes para el transporte, importación y exportación y determinar cuándo es necesario un permiso (licencia) de exportación o importación y cómo conseguirlo. Empaquetado, etiquetado y medio de transporte correctos.
- Normativas de transporte nacional e internacional, importación y exportación,
- Modos de transporte (aire, carretera, tren y agua),
- Tipos de empaquetado y transporte,
- Necesidades de formación.
Tema 4. Preparación y respuesta ante emergencias.
Plan de preparación y respuesta ante emergencias para una situación dada. Las amenazas potenciales resultantes y cómo mitigarlas.
Bioterrorismo
;;;; Clasificación de patógenos en bioterrorismo
;;;; Gestión de crisis; Comunicación del riesgo;
;;;; Crisis del Antrax en España.
;;;; Crisis del Ebola en España
;;;; Respuesta nacional a bioamenazas.
Tema 5. Equipos de protección individual (EPI).
Tipos apropiados de protección personal requeridos para una situación dada, basado en la experiencia teórica y práctica, y discutir posibles problemas y soluciones cuando el equipo es introducido y usado.
- Fundamentos de los EPI,
- Indumentaria,
- Guantes (de laboratorio, para calor/frío, manejo de animales, productos químicos, etc.),
- Protección de la cara y los ojos,
- Zapatos y botas,
- Protección respiratoria (tipos, autorización médica, pruebas de ajuste, mantenimiento, formación),
- Protección del cuerpo.
Tema 6. SARS-CoV-2
;;;; Clasificación
;;;; Envío y recepción de muestras,
;;;; Gestión de muestras para PCR,
;;;; Protección personal en laboratorio,
;;;; Experimentación animal,
;;;; Protección personal.
Tema 7. Errores en instalaciones NCB3
Muestras de errores cometidos en diferentes instalaciones de biocontención
Actividades formativas
Sesiones Expositivas y Dinámicas (Magistrales, MG, en el cronograma)
Trabajos (Seminarios, SM, en el cronograma)
Laboratorios
Consultas y resolución de dudas
Estudio personal
Evaluación
Sistema y criterios de evaluación
Sin perjuicio de que se pueda definir otra exigencia en el correspondiente programa de asignatura, con carácter general, la falta de asistencia a más del 70% de las actividades formativas de la asignatura, que requieran la presencia física o virtual del estudiante, tendrá como consecuencia la pérdida del derecho a la evaluación continua en la convocatoria ordinaria. En este caso, el examen a celebrar en el período oficial establecido por la Universidad será el único criterio de evaluación con el porcentaje que le corresponda según el programa de la asignatura.
----
1. Durante el curso, se realizará una prueba/examen eliminatorio.
2. El examen consistirá en preguntas tipo test y preguntas cortas.
3. La fecha, hora y aula para la realización de la prueba serán comunicados en el aula y mediante un aviso en el campus virtual de la asignatura.
4. Si la nota de la prueba es inferior a 5 o es NP (No Presentado), habrá que repetir la prueba en la Convocatoria Ordinaria (mayo).
5. Si, tras la Convocatoria Ordinaria, la nota sigue siendo inferior a 5, el estudiante estará convocado a acudir a la Convocatoria Extraordinaria (mayo/junio).
Las pruebas y exámenes, así como la presencia a las prácticas de laboratorio son OBLIGATORIAS. La no realización de dichas pruebas y exámenes o la ausencia en los laboratorios, supondrá el suspenso de la asignatura.